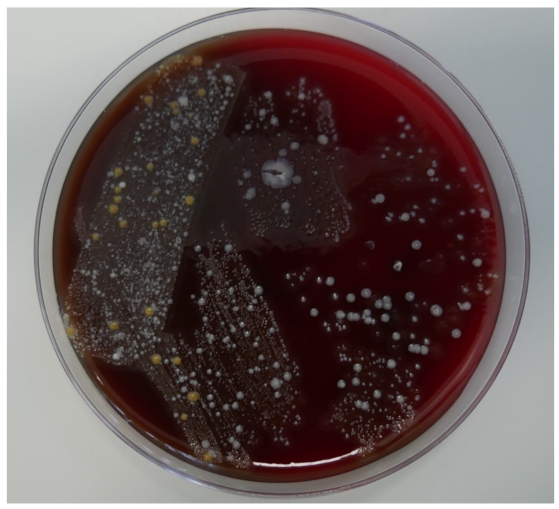
Coatings 12 00909 g008

Radiological and Microbiological Evaluation of the Efficacy of Alveolar Bone Repair Using Autogenous Dentin Matrix—Preliminary Study
Abstract
:1. Introduction
2. Aim of the Study
3. Materials and Methods
3.1. General Information
3.2. Surgery
- Tooth after grinding;
- Tooth after 10 min immersion in cleanser (sodium hydroxide solution with 20% ethanol);
- Tooth after immersion in phosphate-buffered saline;
- Heterogenous bone substitute (comparative study);
- Patient’s own soft tissue (comparative study);
- Patient’s own bone (comparative study)-vestibular bone plate.
3.3. Microbiology
3.4. Data Analysis
3.5. Limitations of Research
4. Results
5. Discussion
6. Conclusions
- The use of an autogenous dentin matrix for alveolar bone repair ensures that the proper volume is obtained and that alveolar bone shape is preserved;
- Two surgical sites do not increase pain in patients and do not cause postoperative healing complications. For minor bone losses, this is one of several solutions that can be proposed to a patient;
- The use of an autogenous dentin matrix, prepared according to the manufacturer’s instructions, does not introduce pathogenic microorganisms into the patient.
Author Contributions
Funding
Institutional Review Board Statement
Informed Consent Statement
Data Availability Statement
Conflicts of Interest
References
- Hnitecka, S.; Hadzik, J.; Smulczyńska-Demel, A.; Szulc, M.; Dominiak, M. Możliwość wykorzystania mielonego zęba jako materiału augmentacyjnego w chirurgii regeneracyjnej wyrostka zębodołowego- opis przypadków. Implants 2017, 4, 14–23. [Google Scholar]
- Del Canto-Díaz, A.; de Elío-Oliveros, J.; Del Canto-Díaz, M.; Alobera-Gracia, M.A.; Del Canto-Pingarrón, M.; Martínez-González, J.M. Use of autologous tooth-derived graft material in the post-extraction dental socket. Pilot study. Med. Oral Pathol. Oral Cir. Bucal. 2019, 24, e53–e60. [Google Scholar] [CrossRef] [PubMed]
- de Molon, R.S.; de Paula, W.N.; Spin-Neto, R.; Verzola, M.H.; Tosoni, G.M.; Lia, R.C.; Scaf, G.; Marcantonio, E., Jr. Correlation of fractal dimension with histomorphometry in maxillary sinus lifting using autogenous bone graft. Braz. Dent. J. 2015, 26, 11–18. [Google Scholar] [CrossRef] [PubMed] [Green Version]
- Wojtowicz, A.; Wychowański, P.; Kuthan, R.; Osiak, M.; Kresa, I. Analiza mikrobiologiczna fragmentów tkanek zęba w procedurze mielenia, procesowania i autotransplantacji GBR. Implants 2017, 3, 6–11. [Google Scholar]
- Haugen, H.J.; Lyngstadaas, S.P.; Rossi, F.; Perale, G. Bone grafts: Which is the ideal biomaterial? J. Clin. Periodontol. 2019, 46 (Suppl. 21), 92–102. [Google Scholar] [CrossRef]
- Moussa, N.T.; Dym, H. Maxillofacial Bone Grafting Materials. Dent. Clin. N. Am. 2020, 64, 473–490. [Google Scholar] [CrossRef]
- Kim, Y.K.; Kim, S.G.; Yun, P.Y.; Yeo, I.S.; Jin, S.C.; Oh, J.S.; Kim, H.J.; Yu, S.K.; Lee, S.Y.; Kim, J.S.; et al. Autogenous teeth used for bone grafting: A comparison with traditional grafting materials. Oral Surg. Oral Med. Oral Pathol. Oral Radiol. 2014, 117, e39–e45. [Google Scholar] [CrossRef]
- Rocchietta, I.; Fontana, F.; Simion, M. Clinical outcomes of vertical bone augmentation to enable dental implant placement: A systematic review. J. Clin. Periodontol. 2008, 35 (Suppl. S8), 203–215. [Google Scholar] [CrossRef]
- Krasny, M.; Krasny, M. Skuteczność autotransplantacji kości jako metody przygotowania zanikłych wyrostków zębodołowych do zabiegu implantacji. MS 2015, 4, 36–39. [Google Scholar]
- Jung, R.E.; Fenner, N.; Hämmerle, C.H.; Zitzmann, N.U. Long-term outcome of implants placed with guided bone regeneration (GBR) using resorbable and non-resorbable membranes after 12–14 years. Clin. Oral Implant Res. 2013, 24, 1065–1073. [Google Scholar] [CrossRef] [Green Version]
- Li, P.; Zhu, H.C.; Huang, D.H. Autogenous DDM versus Bio-Oss granules in GBR for immediate implantation in periodontal postextraction sites: A prospective clinical study. Clin. Implant Dent. Relat. Res. 2018, 20, 923–928. [Google Scholar] [CrossRef] [PubMed]
- Hasegawa, T.; Suzuki, H.; Yoshie, H.; Ohshima, H. Influence of extended operation time and of occlusal force on determination of pulpal healing pattern in replanted mouse molars. Cell Tissue Res. 2007, 329, 259–272. [Google Scholar] [CrossRef] [PubMed]
- Kuperschlag, A.; Keršytė, G.; Kurtzman, G.M.; Horowitz, R.A. Autogenous Dentin Grafting of Osseous Defects Distal to Mandibular Second Molars After Extraction of Impacted Third Molars. Compend. Contin. Educ. Dent. 2020, 41, 76–82, quiz 83. [Google Scholar]
- Kim, S.G.; Kim, Y.K.; Lim, S.C.; Kim, K.W.; Um, I.W. Histomorphometric analysis of bone graft using autogenous tooth bone graft. Implantology 2011, 15, 134. [Google Scholar]
- Santos, A.; Botelho, J.; Machado, V.; Borrecho, G.; Proença, L.; Mendes, J.J.; Mascarenhas, P.; Alcoforado, G. Autogenous Mineralized Dentin versus Xenograft granules in Ridge Preservation for Delayed Implantation in Post-extraction Sites: A Randomized controlled clinical trial with an 18 months follow-up. Clin. Oral Implants Res. 2021, 32, 905–915. [Google Scholar] [CrossRef]
- Hassan, K.S.; Marei, H.F.; Alagl, A.S. Does grafting of third molar extraction sockets enhance periodontal measures in 30- to 35-year-old patients? J. Oral Maxillofac. Surg. 2012, 70, 757–764. [Google Scholar] [CrossRef]
- Shahram, G.; Al Maawi, S.; Śmieszek-Wilczewska, J.; Morawiec, T. Die Rolle des PRF in der weichgewebigen Alveolenheilung. Dent. Implant Parodont. 2020, 24, 142–150. [Google Scholar]
- Clark, D.; Rajendran, Y.; Paydar, S.; Ho, S.; Cox, D.; Ryder, M.; Dollard, J.; Kao, R.T. Advanced platelet-rich fibrin and freeze-dried bone allograft for ridge preservation: A randomized controlled clinical trial. J. Periodontol. 2018, 89, 379–387. [Google Scholar] [CrossRef]
- Su-Gwan, K.; Hak-Kyun, K.; Sung-Chul, L. Combined implantation of particulate dentine, plaster of Paris, and a bone xenograft (Bio-Oss) for bone regeneration in rats. J. Craniomaxillofac. Surg. 2001, 29, 282–288. [Google Scholar] [CrossRef]
- Pang, K.M.; Um, I.W.; Kim, Y.K.; Woo, J.M.; Kim, S.M.; Lee, J.H. Autogenous demineralized dentin matrix from extracted tooth for the augmentation of alveolar bone defect: A prospective randomized clinical trial in comparison with anorganic bovine bone. Clin. Oral Implants Res. 2017, 28, 809–815. [Google Scholar] [CrossRef]
- Ahmed, N.; Gopalakrishna, V.; Shetty, A.; Nagraj, V.; Imran, M.; Kumar, P. Efficacy of PRF vs PRF + Biodegradable Collagen Plug in Post-extraction Preservation of Socket. J. Contemp. Dent. Pract. 2019, 20, 1323–1328. [Google Scholar] [PubMed]
- Kasprzyk-Kucewicz, T.; Cholewka, A.; Bałamut, K.; Kownacki, P.; Kaszuba, N.; Kaszuba, M.; Stanek, A.; Sieroń, K.; Stransky, J.; Pasz, A.; et al. The applications of infrared thermography in surgical removal of retained teeth effects assessment. J. Therm. Anal. Calorim. 2021, 144, 139–144. [Google Scholar] [CrossRef] [Green Version]
- Bramanti, E.; Norcia, A.; Cicciu, M.; Matacena, G.; Cervino, G.; Troiano, G.; Zhurakivska, K.; Laino, L. Postextraction Dental Implant in the Aesthetic Zone, Socket Shield Technique Versus Conventional Protocol. J. Craniofac. Surg. 2018, 29, 1037–1041. [Google Scholar] [CrossRef] [PubMed]
- Morawiec, T.; Dziedzic, A.; Niedzielska, I.; Mertas, A.; Tanasiewicz, M.; Skaba, D.; Kasperski, J.; Machorowska-Pieniążek, A.; Kucharzewski, M.; Szaniawska, K.; et al. The biological activity of propolis-containing toothpaste on oral health environment in patients who underwent implant-supported prosthodontic rehabilitation. Evid. Based Complement Alternat. Med. 2013, 2013, 704947. [Google Scholar] [CrossRef] [PubMed] [Green Version]
- Sánchez-Labrador, L.; Martín-Ares, M.; Ortega-Aranegui, R.; López-Quiles, J.; Martínez-González, J.M. Autogenous Dentin Graft in Bone Defects after Lower Third Molar Extraction: A Split-Mouth Clinical Trial. Materials 2020, 13, 3090. [Google Scholar] [CrossRef]

| Test-Tube | Microorganisms |
|---|---|
| 1. Grounded tooth | Staphylococcus epidermidis MSCNS Streptococcus salivarius |
| 2. Tooth after 10 min in NaOH + 20% ethanol | Staphylococcus epidermidis MSCNS Streptococcus sanguinis |
| 3. Tooth after buffer | Blautia producta |
| 4. Biomaterial | Sarcina spp. |
| 5. Soft tissue | Streptococcus mitis Neisseria subflava |
| 6. Bone | Staphylococcus epidermidis MSCNS Abiotrophia adiacens Streptococcus salivarius |
Publisher’s Note: MDPI stays neutral with regard to jurisdictional claims in published maps and institutional affiliations. |
© 2022 by the authors. Licensee MDPI, Basel, Switzerland. This article is an open access article distributed under the terms and conditions of the Creative Commons Attribution (CC BY) license (https://creativecommons.org/licenses/by/4.0/).
Share and Cite
Kubaszek, B.; Morawiec, T.; Mertas, A.; Wachol, K.; Nowak-Wachol, A.; Śmieszek-Wilczewska, J.; Łopaciński, M.; Cholewka, A. Radiological and Microbiological Evaluation of the Efficacy of Alveolar Bone Repair Using Autogenous Dentin Matrix—Preliminary Study. Coatings 2022, 12, 909. https://doi.org/10.3390/coatings12070909
Kubaszek B, Morawiec T, Mertas A, Wachol K, Nowak-Wachol A, Śmieszek-Wilczewska J, Łopaciński M, Cholewka A. Radiological and Microbiological Evaluation of the Efficacy of Alveolar Bone Repair Using Autogenous Dentin Matrix—Preliminary Study. Coatings. 2022; 12(7):909. https://doi.org/10.3390/coatings12070909
Chicago/Turabian StyleKubaszek, Bartłomiej, Tadeusz Morawiec, Anna Mertas, Kacper Wachol, Anna Nowak-Wachol, Joanna Śmieszek-Wilczewska, Maciej Łopaciński, and Armand Cholewka. 2022. "Radiological and Microbiological Evaluation of the Efficacy of Alveolar Bone Repair Using Autogenous Dentin Matrix—Preliminary Study" Coatings 12, no. 7: 909. https://doi.org/10.3390/coatings12070909
APA StyleKubaszek, B., Morawiec, T., Mertas, A., Wachol, K., Nowak-Wachol, A., Śmieszek-Wilczewska, J., Łopaciński, M., & Cholewka, A. (2022). Radiological and Microbiological Evaluation of the Efficacy of Alveolar Bone Repair Using Autogenous Dentin Matrix—Preliminary Study. Coatings, 12(7), 909. https://doi.org/10.3390/coatings12070909

